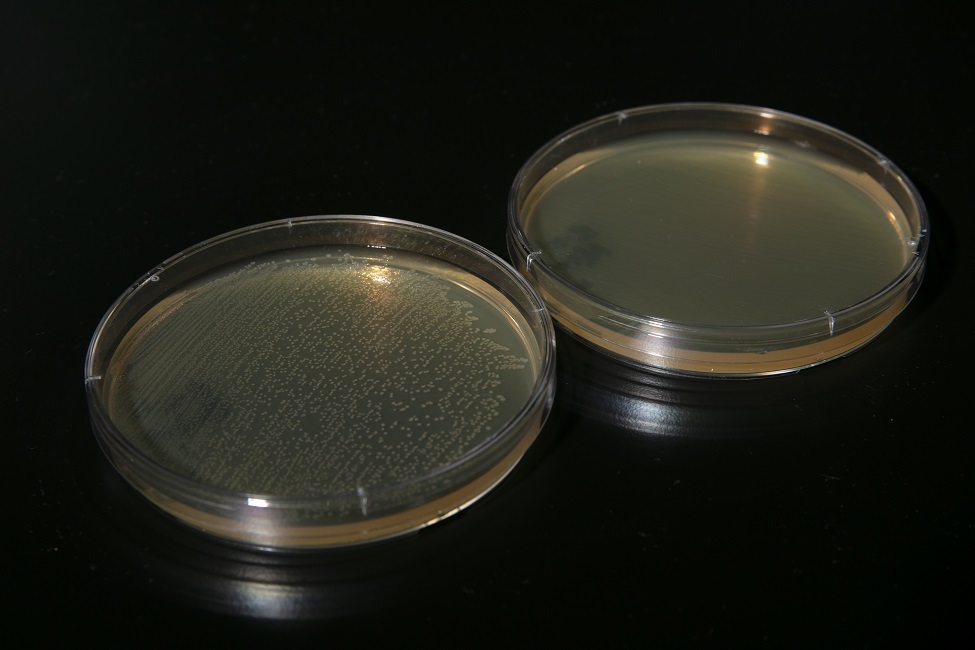
A before and after photo of the highly-contagious E-coli. The researcher tested a number of micro-organisms using this device and has shown its efficacy against pathogens. E-coli was eradicated within the device in about one minute (Photo credit: Alex Dolce)

What’s That Growing on Your Face Mask?

Patrick Grant, Ph.D., associate professor of biomedical science, places face masks into the compact and portable sanitizing device he designed, which can be used at home or at work. (Photo by Alex Dolce)
COVID-19 has significantly increased public use of face masks to protect others from the wearer’s respiratory droplets as well as the wearer from airborne contaminants. After each wear however, bacteria from even a healthy wearer’s own respiratory droplets collect on the inside of a mask as well as the outside, which could contain airborne pathogens capable of living on its surface. Although proper sanitization is imperative, many people reuse masks and other face coverings many times without sanitizing them. That is likely because current sanitization methods can be cumbersome.
To address the many pitfalls of sanitizing all types of face masks from N-95s to cloth and surgical masks, a scientist from Florida Atlantic University’s Schmidt College of Medicine has come up with an innovative solution. Patrick Grant, Ph.D., associate professor of biomedical science, has designed a compact and portable sanitizing device for masks and other items that can be used at home or at work.
The “portable hanging rack device” has been designed as an enclosed chamber that comes in twoforms – a plastic container with a handle and a stainless steel compartment. The hanging rack and an ultraviolet-C (UV-C) light source is placed within either of these enclosed chambers and is capable of sterilizing up to six masks simultaneously and quickly, killing bacteria, yeasts, mold spores, and viruses. The masks are positioned vertically on the internal rack. To prevent the UV light from harming a user’s skin and eyes, the light source is shielded within the housing enclosure. When UV-C radiation contacts the mask, the surface of the mask is subsequently sanitized as the radiation deactivates the biological components of pathogens. The UV-C light source delivers uninterrupted UV-C radiation to the mask surfaces and uses a UV-C bulb that produces limited ozone.
Grant has tested a number of micro-organisms using this device and has shown its efficacy against pathogens including the highly-contagious E-coli, which was eradicated within the device in about one minute. 太阳城娱乐 recently filed a provisional patent application for Grant’s novel invention with the United States Patent & Trademark Office.
“People only have access to a limited supply of masks and often don’t have the option of disposing of them after a single use,” said Grant. “Those who wear cloth masks may sanitize them by washing them, but the washing and drying process is often too time-consuming to sustain washing after each wear. Moreover, washing is not an option for those who wear medical-grade masks, and using disinfectant sprays can cause skin irritation or damage the fibers of the mask designed to catch particulates. That’s why I created this device as a time-efficient way to sanitize facial coverings without damaging their effectiveness and enable wearers to safely reuse them in their daily lives.”
Although there are commercially-available UV-C treatment devices, many of the devices permitting sanitization of multiple objects are of a commercial size that is too large for household use. Furthermore, these devices frequently utilize larger UV bulbs, which are not only costly, but also produce ozone, resulting in an unpleasant odor. In addition, current portable devices are not suitably adapted to sanitize the entire surface of multiple masks at once – a concern for families using multiple face coverings on a daily basis.
While handheld-UV wands exist, these wands increase exposure to UV rays and often require the user to hold the wand for a lengthy period of time to properly sanitize the desired surface, increasing the user’s risk of skin burns and damage to the corneas of the eyes. Studies also have shown users of hand-held devices are unable to hold the devices at the angle and for the length of time necessary to generate a stable UV directional output and effectively sanitize a surface. Moreover, open-air UV devices risk UV exposure to commonly found household surfaces such as plastics, which may damage the integrity and appearance of these materials.
When fully developed, this apparatus will effectively sanitize masks as well as other objects such as keys and smart phones in a way that is safe, affordable, odor-free, and suitable for household use. Grant anticipates the cost of the plastic portable container and the steel container to be under $100 and to provide cost savings from an extended life of masks and from potential savings from reducing preventable infections.
-太阳城娱乐-
Tags: coronavirus | faculty and staff | technology | research | medicine